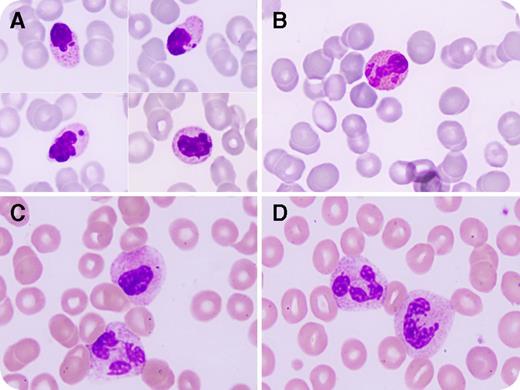
A previously healthy 45-year-old woman presented with severe abdominal pain, diarrhea, and vomiting persisting 12 hours after ingestion of a homemade vegetable juice. Seventy-two hours later, she developed hemiparesis and multiple organ failure with renal and hepatic insufficiency, leading to encephalopathy and coma. Laboratory analysis showed pancytopenia (white blood cell count, 1.2 × 109/L; neutrophils, 1.0 × 109/L; hemoglobin, 11.5 g/dL; and platelets, 32 × 109/L). A peripheral blood smear showed neutrophils and eosinophils of markedly reduced size with loss of segmentation, condensed chromatin, and nuclear fragmentation, whereas the cytoplasm was granular and often exhibited large inclusions (panels A-B; original magnification ×1000, May-Grünwald Giemsa stain). / The patient’s history and drug screening disclosed colchicine intoxication following the accidental ingestion of 200 mL of juice made of 40 pressed Colchicum autumnale leaves, which were mistaken for wild garlic plant (Allium ursinum). Twenty-four hours later, the serum level of colchicine was 12.15 μg/L (lethal dose, 9-24 μg/L). The morphologic anomalies in the neutrophils and eosinophils were most likely due to colchicine, which inhibits microtubule polymerization and triggers cell apoptosis. Two months later, most neutrophils had a normal morphology, with rare cells still showing pseudo–Pelger-Huët anomalies (panels C-D; original magnification ×1000, May-Grünwald Giemsa stain). Colchicine intoxication should be considered in patients who exhibit reduced-size neutrophils and condensed chromatin.

A previously healthy 45-year-old woman presented with severe abdominal pain, diarrhea, and vomiting persisting 12 hours after ingestion of a homemade vegetable juice. Seventy-two hours later, she developed hemiparesis and multiple organ failure with renal and hepatic insufficiency, leading to encephalopathy and coma. Laboratory analysis showed pancytopenia (white blood cell count, 1.2 × 109/L; neutrophils, 1.0 × 109/L; hemoglobin, 11.5 g/dL; and platelets, 32 × 109/L). A peripheral blood smear showed neutrophils and eosinophils of markedly reduced size with loss of segmentation, condensed chromatin, and nuclear fragmentation, whereas the cytoplasm was granular and often exhibited large inclusions (panels A-B; original magnification ×1000, May-Grünwald Giemsa stain).
The patient’s history and drug screening disclosed colchicine intoxication following the accidental ingestion of 200 mL of juice made of 40 pressed Colchicum autumnale leaves, which were mistaken for wild garlic plant (Allium ursinum). Twenty-four hours later, the serum level of colchicine was 12.15 μg/L (lethal dose, 9-24 μg/L). The morphologic anomalies in the neutrophils and eosinophils were most likely due to colchicine, which inhibits microtubule polymerization and triggers cell apoptosis. Two months later, most neutrophils had a normal morphology, with rare cells still showing pseudo–Pelger-Huët anomalies (panels C-D; original magnification ×1000, May-Grünwald Giemsa stain). Colchicine intoxication should be considered in patients who exhibit reduced-size neutrophils and condensed chromatin.
A previously healthy 45-year-old woman presented with severe abdominal pain, diarrhea, and vomiting persisting 12 hours after ingestion of a homemade vegetable juice. Seventy-two hours later, she developed hemiparesis and multiple organ failure with renal and hepatic insufficiency, leading to encephalopathy and coma. Laboratory analysis showed pancytopenia (white blood cell count, 1.2 × 109/L; neutrophils, 1.0 × 109/L; hemoglobin, 11.5 g/dL; and platelets, 32 × 109/L). A peripheral blood smear showed neutrophils and eosinophils of markedly reduced size with loss of segmentation, condensed chromatin, and nuclear fragmentation, whereas the cytoplasm was granular and often exhibited large inclusions (panels A-B; original magnification ×1000, May-Grünwald Giemsa stain).
The patient’s history and drug screening disclosed colchicine intoxication following the accidental ingestion of 200 mL of juice made of 40 pressed Colchicum autumnale leaves, which were mistaken for wild garlic plant (Allium ursinum). Twenty-four hours later, the serum level of colchicine was 12.15 μg/L (lethal dose, 9-24 μg/L). The morphologic anomalies in the neutrophils and eosinophils were most likely due to colchicine, which inhibits microtubule polymerization and triggers cell apoptosis. Two months later, most neutrophils had a normal morphology, with rare cells still showing pseudo–Pelger-Huët anomalies (panels C-D; original magnification ×1000, May-Grünwald Giemsa stain). Colchicine intoxication should be considered in patients who exhibit reduced-size neutrophils and condensed chromatin.
For additional images, visit the ASH IMAGE BANK, a reference and teaching tool that is continually updated with new atlas and case study images. For more information visit http://imagebank.hematology.org.

This feature is available to Subscribers Only
Sign In or Create an Account Close Modal